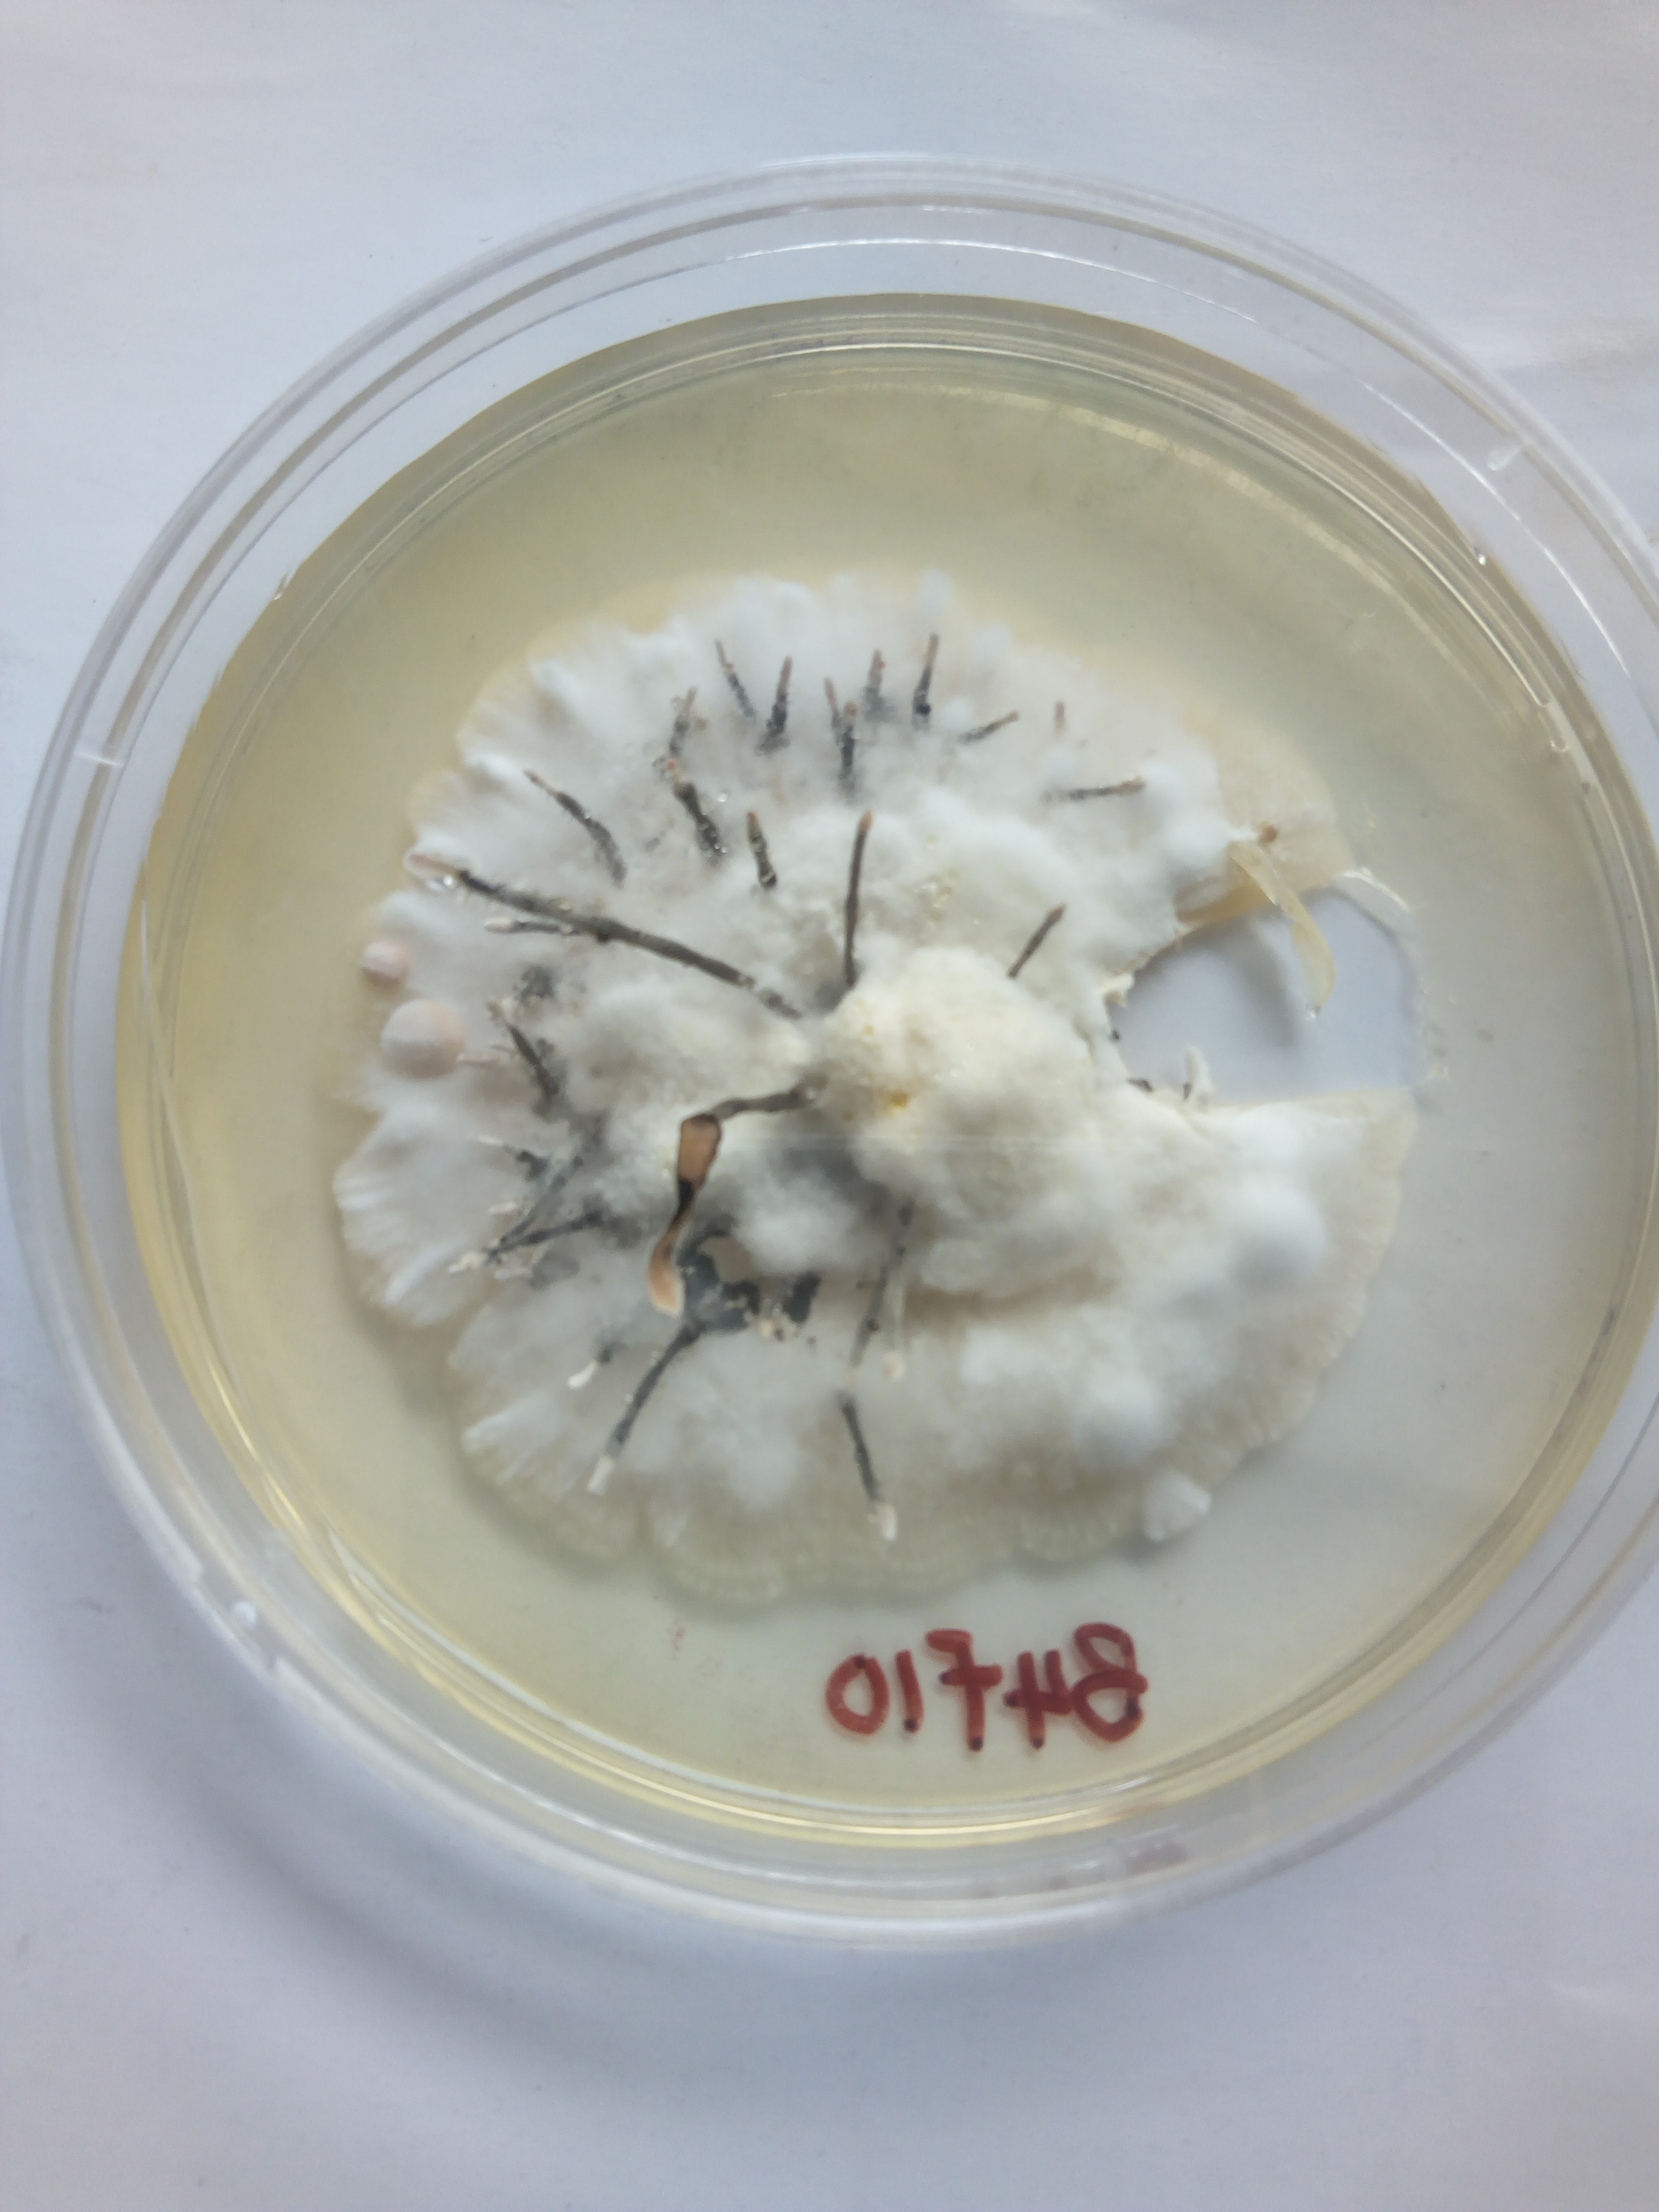
featured

makovicloyal (44)
love to know different stuffs and i love to share my thoughts and knowledge
189 followers153 posts150 following7 HP
Blacklisted UsersMuted UsersFollowed BlacklistsFollowed Muted Lists
Blacklisted UsersMuted UsersFollowed BlacklistsFollowed Muted Lists
Joined May 2018 Active 7 years ago